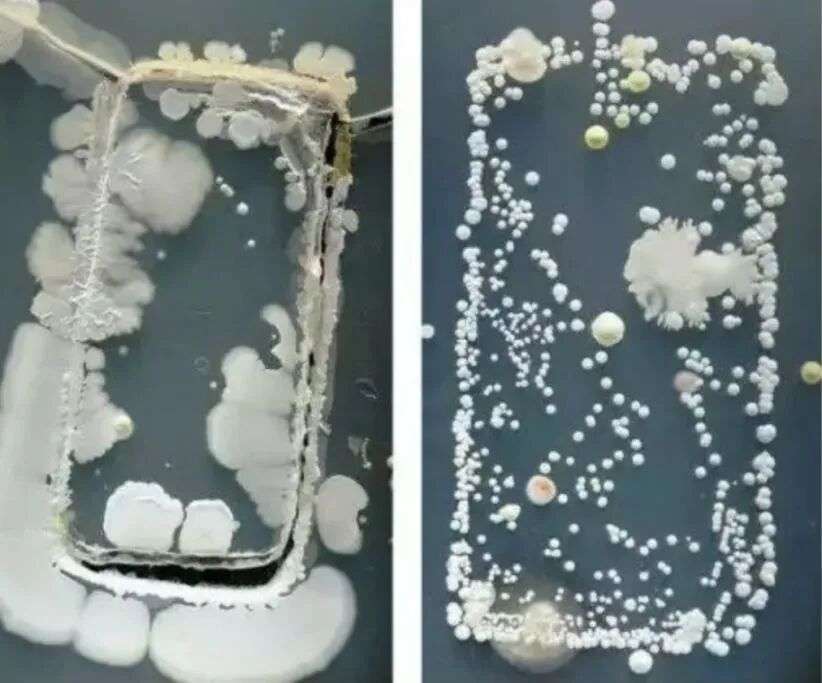
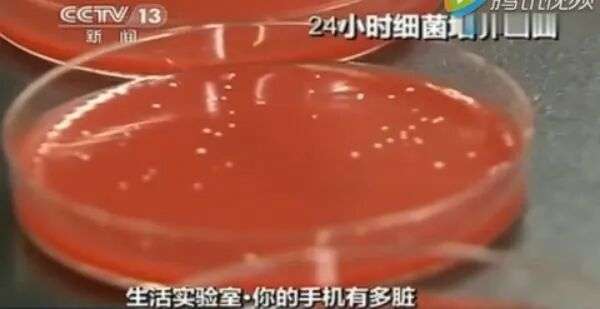
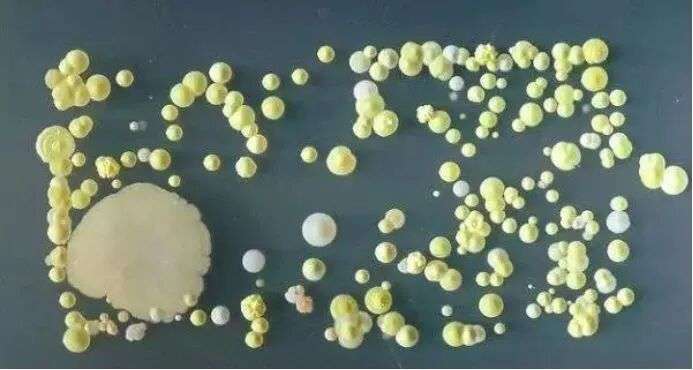
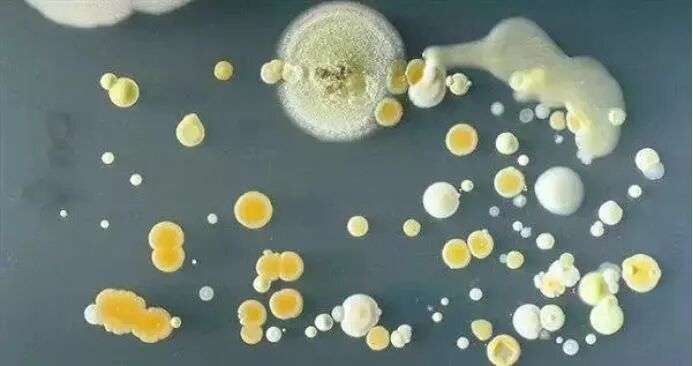
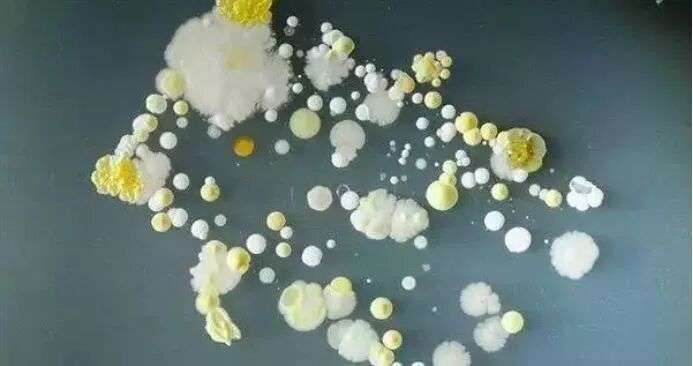
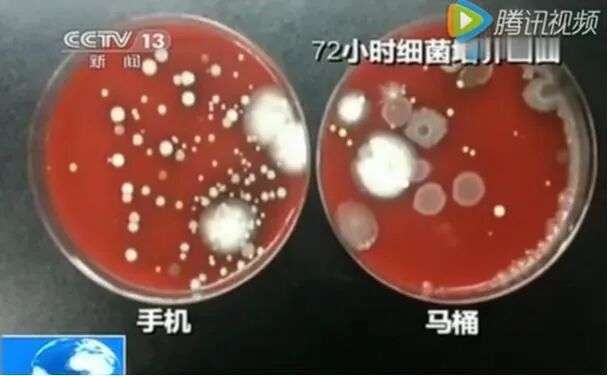

收藏澳媒警告: 每个人天天都用的东西, 充满病毒! 我们还抱着吃饭!
家里最脏的东西,竟然不在厕所!而且每个人每天都要密切接触,离了它都不行!
01
如今大家对手机的依赖越老越强烈,睡觉前刷手机也成了很多人入睡前的习惯,想戒都戒不掉。
但是最近,澳洲媒体的一篇报道称,科学家已经发出了警告:
你以为睡前玩手机仅仅是影响睡眠吗?背后还藏着更可怕的隐患!

图片来源:Daily Mail
根据MattressNextDay赞助的研究,手机上可能藏有通常在蟑螂粪便中发现的有害细菌。接触这些细菌可能会导致皮疹、肺炎,甚至在易感个体中引发败血症。
更糟的是,科学家警告说,床上的温暖潮湿环境是这些病原体滋生和传播的理想“培养皿”。平均每人每天触摸手机约2,617次,这也是让手机变得极度不卫生的主要原因。
此前还有研究发现,手机可以携带的细菌数量是马桶座圈的十倍。

图片来源:Daily Mail
为了确切了解手机等人们密切接触的电子设备可能藏着什么样的细菌,研究人员对十部智能手机和十块智能手表进行了拭子采样。
然后在实验室中培养这些细菌,以确定存在哪些微生物。
结果表明,智能手机是最脏的科技产品,其上细菌的数量甚至超过了此前在遥控器等常见病菌聚集地上发现的细菌。
在手机、手表和Fitbit上发现的最常见细菌是铜绿假单胞菌,这种细菌通常存在于蟑螂粪便中。
早前的研究发现,医院里捕捉到的蟑螂中,有八分之一携带这种潜在有害的细菌。这对于数百万把手机带到床上的人来说尤其令人担忧。

图片来源:Daily Mail
一项由Mattress Next Day 对575名成人进行的调查发现,74%的受访者在头旁或枕头下睡觉时放着手机。
科学家警告说,这可能让你暴露在手机上潜在的有害细菌中。更糟糕的是,铜绿假单胞菌在床上的温暖、潮湿环境中茁壮成长。
研究发现,普通人每晚出汗量可达700毫升,床上的温度通常可达到20摄氏度。这为细菌的生长和潜在感染创造了理想环境。
图片来源:Daily Mail
虽然铜绿假单胞菌在大多数情况下是无害的,但它可能引发更严重的健康并发症。暴露于这种细菌可能导致眼部感染、皮疹、脓疱、腹泻、头痛等症状。
对于免疫系统较弱的人,后果可能更加严重。铜绿假单胞菌可能会在易感个体中引发各种感染,包括肺炎、尿路感染,甚至败血症。
在医院环境中,这种源自蟑螂的细菌是患者感染的主要原因之一,尤其是健康状况较差的患者。
更糟的是,这种细菌以其抗生素抗性而闻名,使得感染更加难以治疗。
图片来源:网络
央视还曾经报道过这么一个实验,视频中,记者将随机把人们身上的手机进行采样,有出租车司机的手机,小朋友玩游戏的手机等等。
把手机上采集的细菌均匀地涂抹在培养皿上,将他们放进恒温恒湿的孵箱之内,静待观察。
一个24时过去了,大部分的手机的培养皿上出现了小如针尖,大如小米大小的菌落。但是一部经常被主人擦拭的手机的培养皿却非常干净,与之前并无区别。
第二个24小时过去了,之前没有什么变化的培养皿也未能幸免,同时也长出了许多肉眼可见的菌落。而之前针尖大小的菌落,变成了米粒大小。
在经过了第三个24小时,可以发现送检的每一个培养皿中都出现了不同颜色以及大小清晰的菌落,最大的有硬币大小。
不过专家表示,人们可以采取一些简单的措施来减少感染风险。
例如定期使用酒精湿巾或紫外线消毒器清洁手机,可以消除设备上可能存在的细菌。特别要注意那些与你面部接触的区域,如手机屏幕或智能手表表带。

图片来源:Daily Mail
清洁手机在减少感染方面非常有效,以至于日本成田国际机场曾经试验引入“智能手机专用卫生纸”。这些卫生纸放置在普通卫生纸旁,可以用来擦掉手机在卫生间中可能沾染的细菌。
但是对手机的清洁,在日常生活中往往被很多人忽略了。调查发现,51%的人从未清洁过他们的智能手机。
此外,减少接触有害细菌的另一个简单方法是减少手机与面部接触的次数。这可能包括将手机放在床外,或者在睡前定期休息,不使用电子设备。
02
在我们认识中,你认为什么东西是最脏的?
是马桶么?
事实可能会颠覆你的认知!
美国芝加哥大学微生物生态学家杰克·吉尔伯特也曾经做过一个实验,在各种我们认为非常脏的表面上监视观察细菌病毒的形成过程,其中包括水盆,马桶圈还有厕所地面。
而结果,却很难让人相信,在人类正常活动的状态下,厕所的细菌病毒的密度并没有反常增长,反而会在八周之内下降到正常水平之下,而是在餐厅卧室之类的地方往往细菌病毒会增长的挺快…

图片来源:网络
吉尔伯特发现,68%至98%的菌群都与皮肤和户外环境有关,最多有15%源自排泄物,只要不是拉屎拉到了外面,大肠杆菌都不会明显增长。
马桶属于使用频率很高,人们很注意的东西,所以定期会有人进行清理,对其表面进行消毒,所以微生物细菌病毒之类的并不能大面积生长。
图片来源:腾讯视频
而相反的,那些使用频率很高,而人们也不会特别注意的东西,如门把手,还有我们经常拿在手里的手机,这些东西反倒是细菌最为钟爱的地方!
甚至可能连澳洲海关都要加强手机可能给澳洲带来的生物安全风险的关注。
最后归根结底,这些细菌什么的还都是从我们手上来的,无论是手机还是门把手上,其实都是人类活动造成的细菌蔓延。
看起来脏的东西,也只是让人感官上有所不适,但是我们最为倚重的双手才是真正的病原,如何能让手机上菌落不再泛滥,首先要勤洗手,其次多清洁手机。
本文为转载发布,仅代表原作者或原平台态度,不代表我方观点。澳洲印象仅提供信息发布平台,文章或有适当删改。对转载有异议和删稿要求的原著方,可联络 [email protected]




















你需要登录后才能评论 登录